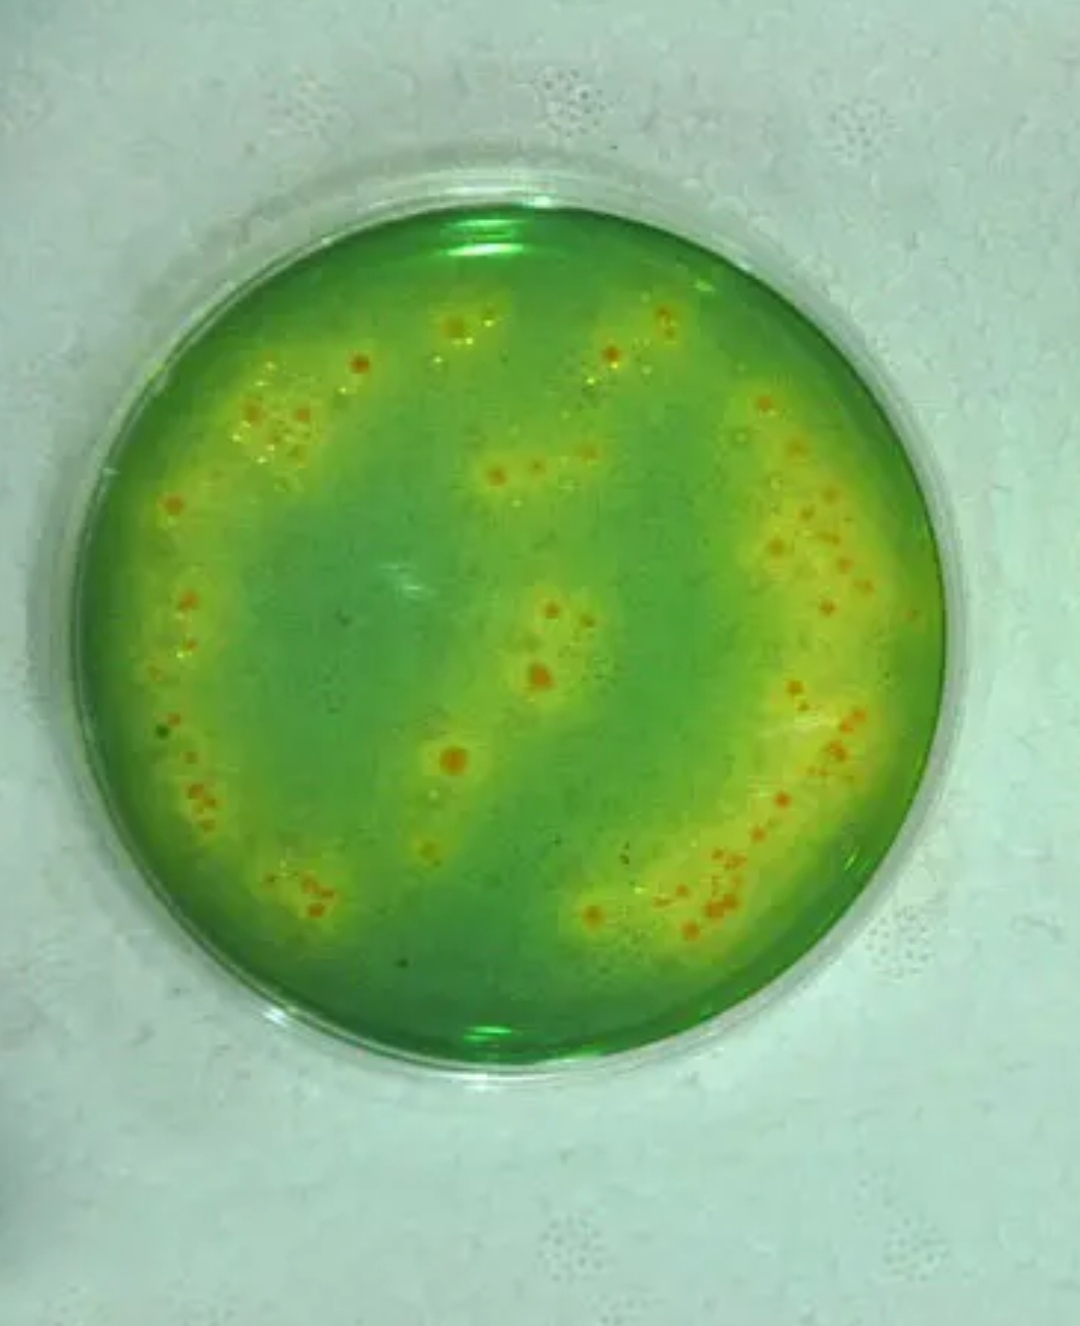
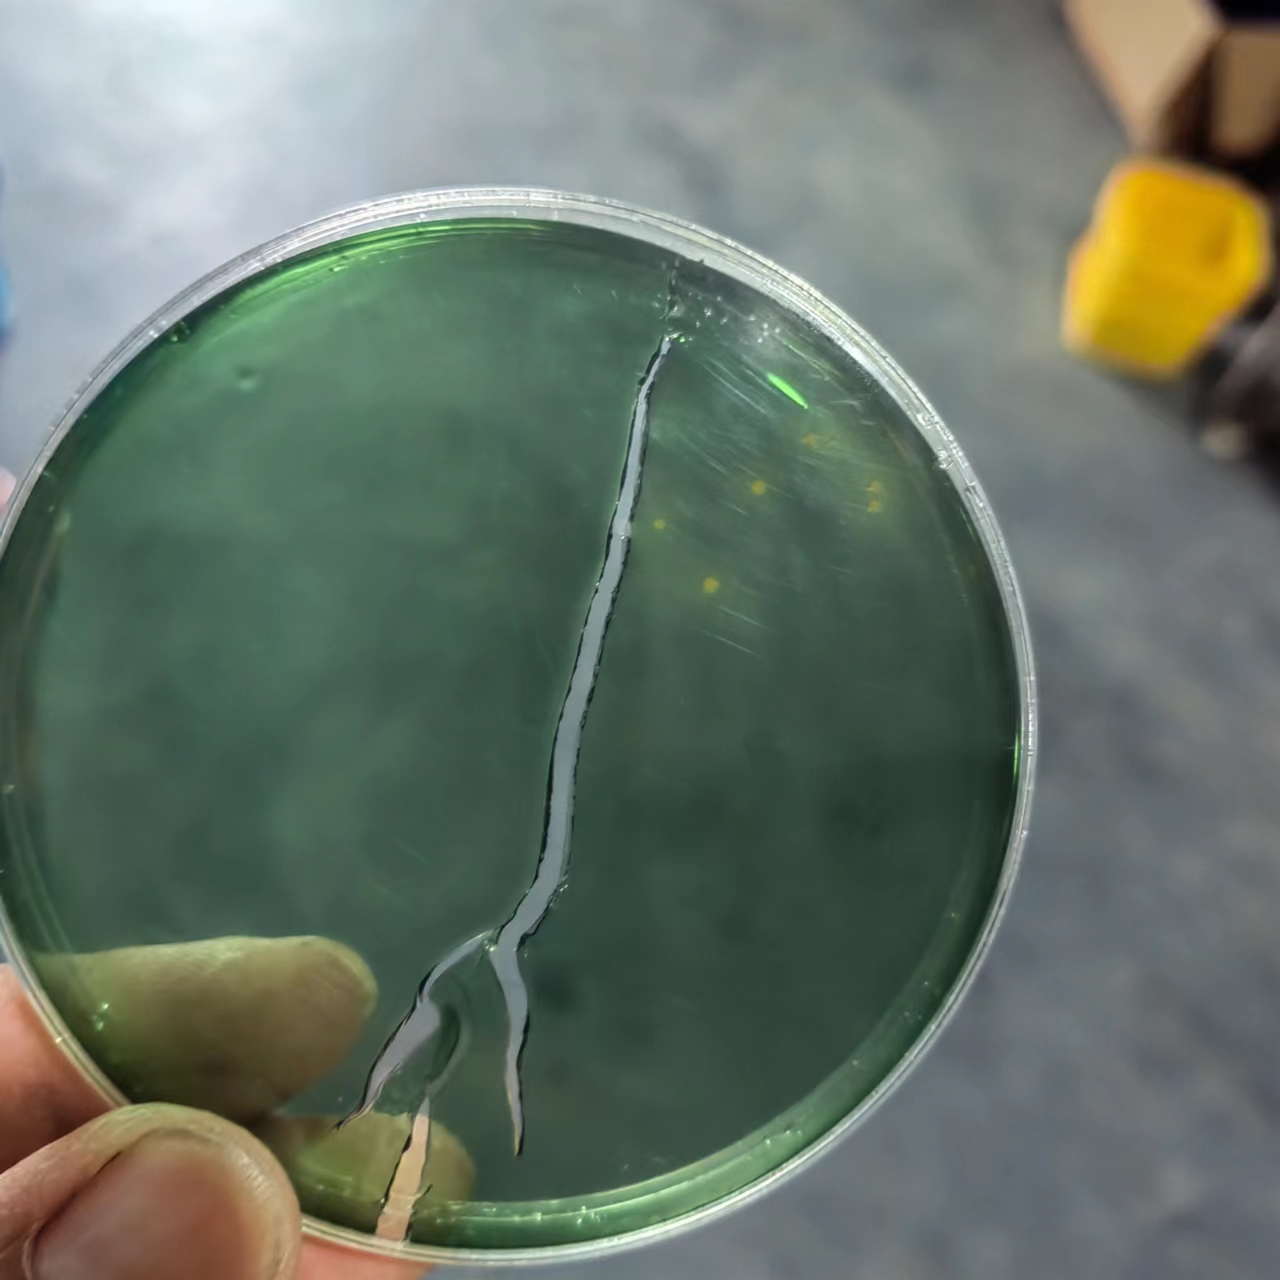

一,案例详情
时间,2023,8月2号
地点,山东东营
面积,40张棚
二,实际情况
通过检测,有一定数量黄弧菌,少量绿弧菌
三,处理方案
弧立净1甁每棚外泼,隔3天再使用一次
连续内服5天,5毫升/斤料,每天一次

四,使用效果
8月7号检测
五,案情分析
水体弧菌和虾体弧菌密切相关,一般情况下水体弧菌超标虾体弧菌也会超标。水体弧菌主要通过摄食不断富集到虾子体内,弧菌大量繁殖很快感染虾子肝脏、肠道等重要器官,导致虾子出现各种病症,处理弧菌问题,必须要水体弧菌和虾体弧菌同步处理。
本文供稿:孙树平,马玉克
编辑审核:臧学运,张传宝

